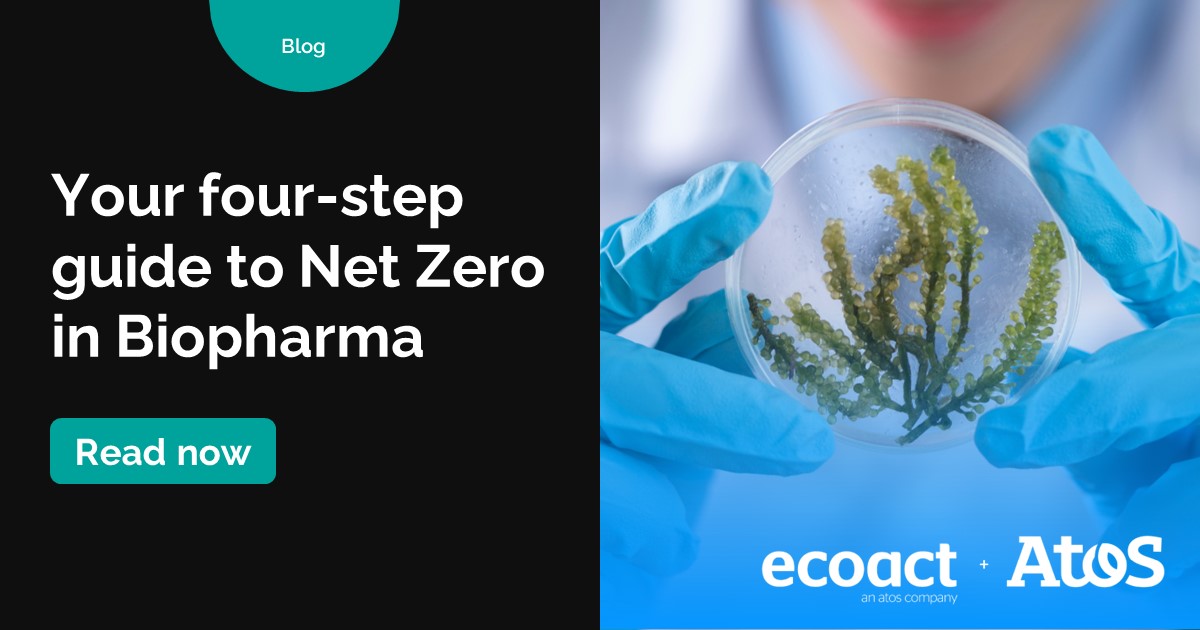
Discover Atos's prescription for achieving #NetZero in #biopharma. Our four-step approach can help your organization align with best practices and increase its #climate resilience ➡️ atos.net/en/blog/ecoact….

Dave Holton
@holtontech
Client Exec for Energy and Utilities @ #Atos #Digital #Digitaltwin #AI #IoT #Industry40 #energy #leadership #utilities #WeareAllies All views are my own
ID: 784055028248182785
http://atos.net 06-10-2016 15:37:40
4,4K Tweet
1,1K Takipçi
517 Takip Edilen





Vaping Product Classification - Sign the Petition! chng.it/gQTjVyqF via Change.org UK










“Successful leaders are curious about others and learning how others do things so that they, the leaders, can learn and become better versions of themselves.”&hashtags=QuoteOfTheDay mck.co/41m7MHe via McKinsey & Company




🖧 Scottish Water needed a new, modern #network strategy that was less reliant on legacy technologies. It was a pleasure for us to deploy their new network strategy ensuring network stability, resilience, and flexibility. Discover more 👉 atos.net/en/client-stor…

![Dave Holton (@holtontech) on Twitter photo [#EmployeeExperience] 🔎 If you are looking to make a step change in Employee Experience, we can help! See how Gartner rates our capabilities ➡️ atos.net/en/lp/leader-i…
#DigitalWorkplace #FutureOfWork #Gartner [#EmployeeExperience] 🔎 If you are looking to make a step change in Employee Experience, we can help! See how Gartner rates our capabilities ➡️ atos.net/en/lp/leader-i…
#DigitalWorkplace #FutureOfWork #Gartner](https://pbs.twimg.com/media/FtBDSiPWYAMugcf.jpg)

![Dave Holton (@holtontech) on Twitter photo [#EmployeeExperience] 👨💼 With its holistic #workplace services offering, we focus on employee experience with a commitment to deliver business outcomes, technical innovation & strong commercial terms. Download the #DigitalWorkplace #FutureOfWork report. atos.net/en/lp/leader-i… [#EmployeeExperience] 👨💼 With its holistic #workplace services offering, we focus on employee experience with a commitment to deliver business outcomes, technical innovation & strong commercial terms. Download the #DigitalWorkplace #FutureOfWork report. atos.net/en/lp/leader-i…](https://pbs.twimg.com/media/FuoEeNkWwAAbrW7.jpg)



![Dave Holton (@holtontech) on Twitter photo [Company News 📰🎊]
Atos is proud to announce its 2-year contract extension with TxDIR for our Texas Private Cloud and Mainframe Services! [Company News 📰🎊]
Atos is proud to announce its 2-year contract extension with TxDIR for our Texas Private Cloud and Mainframe Services!](https://pbs.twimg.com/media/Fwuk8V6XoAEeDTn.jpg)